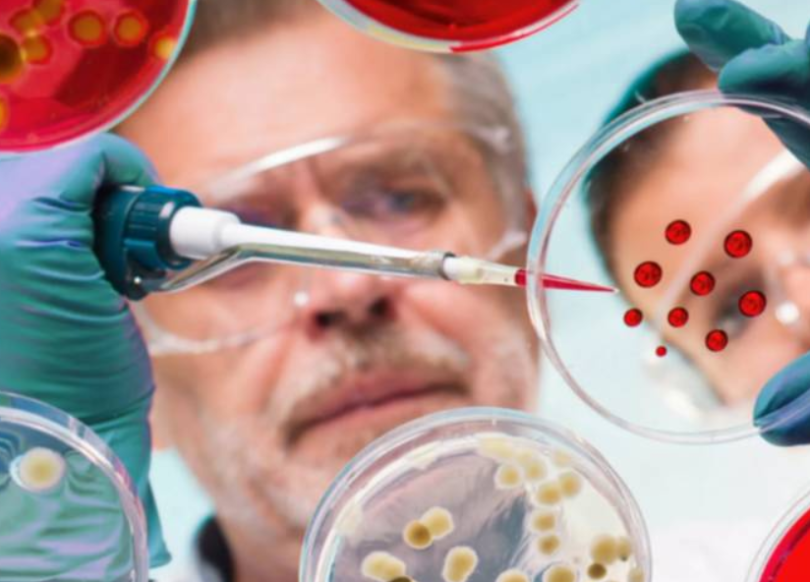
koronavirus-1

Новый штамм, угроза третьей волны и банкетные залы
6 апреля состоялось заседание Оперативного штаба по противодействию распространению новой коронавирусной инфекции на территории Республики Дагестан.
Одной из важнейших тем стало заявление главного санитарного врача Николая Павлова, который сообщил что на территории Дагестана обнаружились больные инфицированные новым британским штаммом COVID-19. Отметим, что новый штамм коронавирусной инфекции был найден у двух человек, прибывших в Дагестан из-за границы, оба излечены, а 26 человек, контактировавших с ними, находятся под наблюдением.
По мнению главного санитарного врача Республики, все прибывшие в Дагестан из-за границы должны в течение трех дней после приезда проходить обследование и размещать соответствующую информацию на портале Госуслуг. Однако многие это предписание игнорируют. Так Павлов предложил осуществлять организацию забора биоматериала на территории махачкалинского аэропорта при помощи Минздрава РД или частных клиник.
В свою очередь врио Главы Дагестана добавил: «К сожалению, пока не удается добиться устойчивого снижения числа заболевших. Мы держимся на уровне 40-45 заболеваний в день». В связи с этим Павлов предложил сохранить масочный режим и ограничения на работу банкетных залов, сообщила пресс-служба главы Дагестана.
Вместе с тем главный санитарный врач отметил, что в других странах отмечается прирост заболеваемости, поэтому угроза третьей волны по-прежнему существует.
По данным сайта «Стопкоронавирус.рф» на 6 апреля, в Дагестане зарегистрировано 31304 случая заражения COVID-19, в том числе 40 – за сутки. Выздоровели с начала пандемии 28964 пациента, умерли 1414 человека.
Напомним, новая мутация коронавируса SARS-CoV-2 была выявлена в Великобритании в середине декабря 2020 года. Консультационный совет по новым и возникающим респираторным вирусным угрозам Британии подтвердил, что этот вариант коронавируса распространяется с большей скоростью и требует от населения еще большей осторожности. Хотя новый штамм, по предварительным оценкам, может быть на 70% заразнее обычного, ничто пока не говорит о том, что он более опасен с точки зрения смертности или госпитализации.
Также на заседании оперштаба Сергей Меликов отметил низкие темпы вакцинации. На сегодняшний день в республике всего привито всего 32 655 человек. Особо важно, убежден Меликов, сохранять повышенное внимание к вакцинации с учетом предстоящих мероприятий, посвященных майским праздникам, а также организации очередной хадж-миссии.
«Надеемся, что у нас будет возможность полноценно, но при этом взвешенно, провести все предусмотренные акции. А их достаточно. Это и «Вахта памяти», «Бессмертный полк», парад в Каспийске и некоторые другие мероприятия. Кроме того, мы готовимся к открытию туристического сезона. Надо помнить о том, что со второй половины мая наплыв туристов в Дагестан будет положительно сказываться не только на имидже республики, но и, прежде всего, на экономике региона, давая новые возможности малому предпринимательству», – подчеркнул Сергей Меликов.

Добавить комментарий